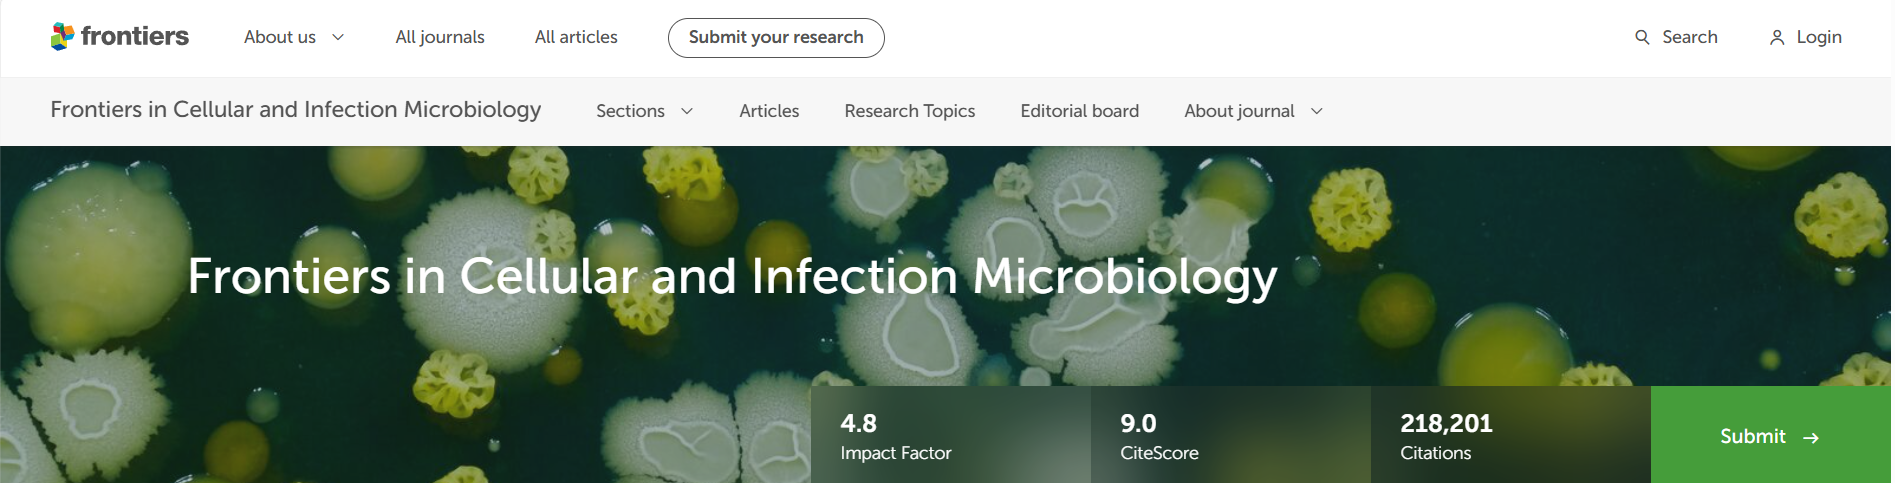

来源:特诺科研
期刊官网:http://journal.frontiersin.org/journal/cellular-and-infection-microbiology


专注期刊投稿、发表十年,任何投稿、写作难题欢迎咨询!

PAPER INFORMATION
快速预审、投刊前指导、专业学术评审,对文章进行评价
校对编辑、深度润色,让稿 件符合学术规范,格式体例等标准
适用于语句和结构尚需完善和调整的中文文章,确保稿件达到要求
数据库包括: 期刊、文书籍、会议、预印章、书、百科全书和摘要等
让作者在期刊选择时避免走弯路,缩短稿件被接收的周期
根据目标期刊格式要求对作者文章进行全面的格式修改和调整
帮助作者将稿件提交至目标期刊投稿系统,降低退稿或拒稿率
按照您提供的稿件内容,指导完成投稿附信(cover letter)
北京总部:北京市海淀区碧桐园 3 号楼 2 层 211 广州办事处:广州市黄埔区科学城国际企业孵化器 E栋306 联系人:客服 / 18163670350
Copyright © 2022-2024 北京特诺科技有限公司 版权所有 备案/许可证编号为: 京 ICP 备 2023007944 号